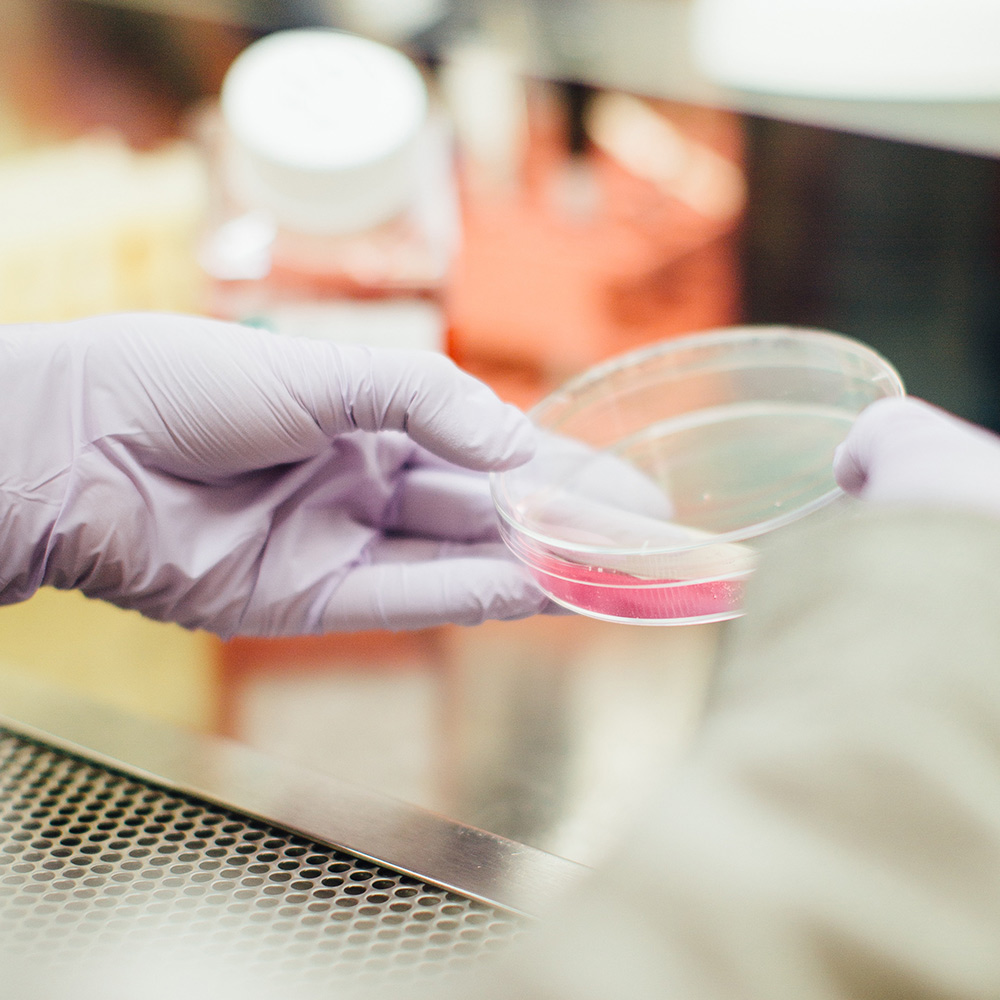
Clinically proven dental care product

Tartar Shield
Tartar Shield patented products were developed by a leading dental scientist, Dr. George K. Stookey.

Made in the USA with US ingredients
Clinically proven dental care products

Your pets will love Tartar Shield!
Periodontal Disease is the number one health problem diagnosed in pets and according to the American Veterinary Dental Society (AVDS), it affects nearly 80% of dogs and cats over the age of three. Bacteria and plaque can progress into bleeding gums, tooth loss, and can even cause damage to the heart and other internal organs.


